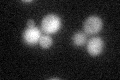
YLR231C
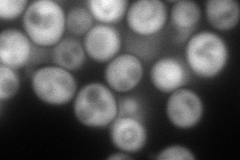
YLR231C
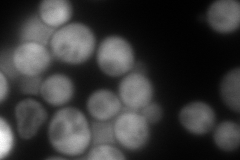
YLR231C
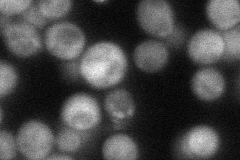
YLR231C
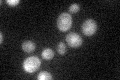
YLR231C

View description
Kynureninase, required for the de novo biosynthesis of NAD from tryptophan via kynurenine; expression regulated by Hst1p
Localization:
Intensity:
Fold change:
Significance:
-
C’ GFP library in SD
cytosol40.09 -
N' NOP1pr-GFP in SD
cytosol185.522 -
N' TEF2pr-mCherry in SD
cytosol305.434 -
N' NATIVEpr-GFP in SD
cytosol50.0536 -
N' TEF2pr-VC and Cyto-VN in SD

#N/A0 -
C’ GFP library in SD+DTT

cytosol53.081.32No -
C’ GFP library in SD+H2O2

cytosol34.910.87No -
C’ GFP library in Starvation Media
cytosol37.570.93No -
C’ GFP library on the background of Pup2-DaMP

cytosol -
C’ GFP library on the background of CCT mutant

cytosol32.27780.804967No
